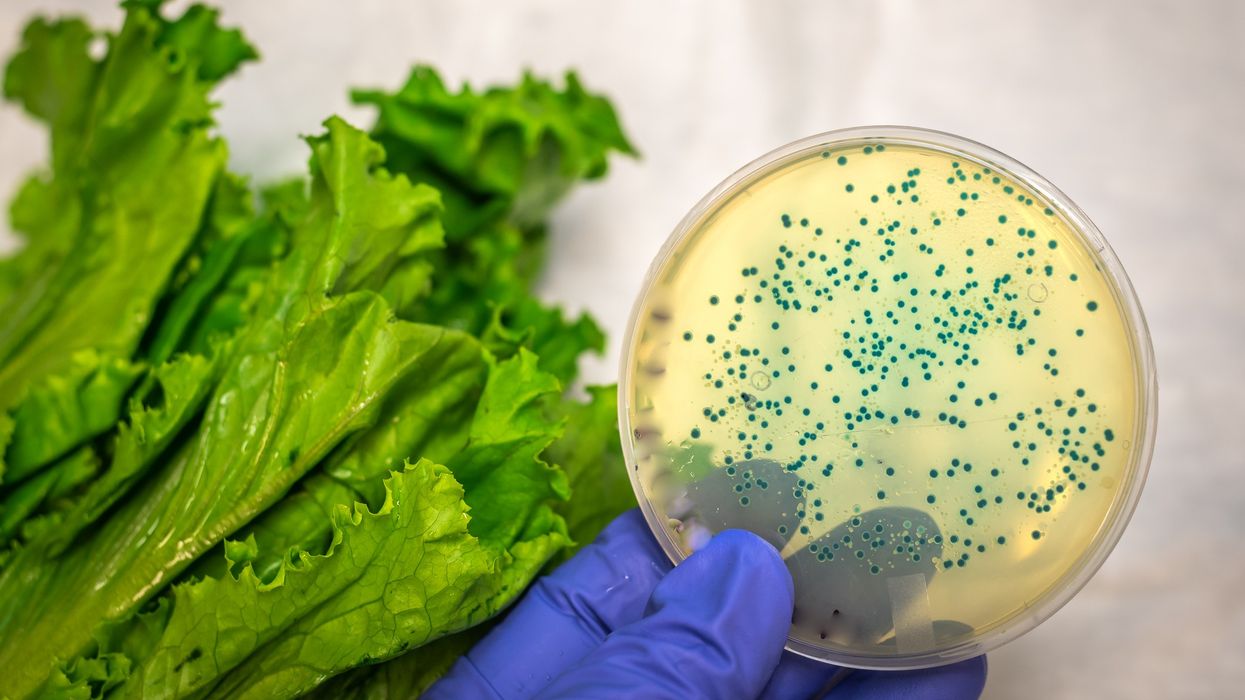
E. coli

Highlights
- E. coli infections rose by 26% in 2024, with over 2,500 cases reported in England
- Outbreaks linked to supermarket salad leaves, contaminated beef and fresh fruit
- Two deaths and over 120 hospitalisations reported in largest outbreak
- Children aged 1–4 most affected, with 357 confirmed cases
- Experts advise strict hygiene and food safety measures to curb spread
Cases of Shiga toxin-producing E. coli (STEC) rose by over a quarter in England last year, according to data from the UK Health Security Agency (UKHSA). A total of 2,544 cases were confirmed in 2024, up from 2,018 in 2023—a 26% increase.
The rise is partly attributed to multiple foodborne outbreaks, with supermarket salad leaves identified as the leading cause of the largest incident.
Salad-linked outbreak leads to deaths and hospitalisations
The UKHSA investigated five outbreaks of STEC last year, involving 467 confirmed cases, of which 348 were in England. Contaminated salad leaves, beef and fresh fruit were among the sources.
The largest outbreak, linked to pre-packaged salad leaves, resulted in 196 confirmed cases in England alone. Across all outbreaks, 126 individuals required hospital treatment and two people died. More than a dozen supermarket products were recalled as a precaution.
Young children and travellers among the most affected
Children aged one to four years old were the most impacted demographic, accounting for 357 cases. Experts cite lower immunity, less developed hygiene practices, and a higher likelihood of seeking medical care as contributing factors.
STEC cases linked to foreign travel also rose sharply, increasing by 60%, with 183 travel-related cases reported last year.
Health experts issue hygiene warning
Dr Gauri Godbole of the UKHSA urged the public to take preventive measures, emphasising the importance of hygiene at home and abroad.
“STEC cases rose by around a quarter in 2024. While this rise is partly due to one foodborne outbreak, we have been seeing STEC cases gradually increase since 2022, and therefore it’s important for people to take steps to prevent infection.”
She added that symptoms—including diarrhoea (sometimes bloody), stomach cramps, vomiting and dehydration—should be taken seriously.
“Wash your hands with soap and warm water, clean surfaces with bleach-based products, and avoid preparing food for others if you are symptomatic or within 48 hours of recovery.”
Parents are advised to ensure children wash their hands thoroughly, especially before eating, after playing outdoors, or after visiting petting farms.